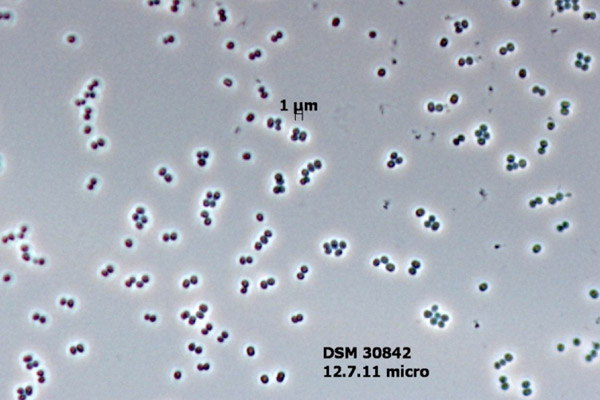

The Cape Melville leaf-tailed gecko (Saltuarius eximius) is one of the top ten new species from 2013. Photo by: Conrad Hoskin.
Out of around 18,000 new species described and named last year, scientists have highlighted ten in an effort to raise awareness about the imperiled biodiversity around us. Each species—from a teddy-bear-like carnivore in the Andes to a microbe that survives clean rooms where spaceships are built—stands out from the crowd for one reason or another. The top ten list is an annual event by the SUNY College of Environmental Science and Forestry’s (ESF) International Institute for Species Exploration (IISE).
“The majority of people are unaware of the dimensions of the biodiversity crisis,” said Quentin Wheeler, founding director of the IISE and ESF president. “The top ten is designed to bring attention to the unsung heroes addressing the biodiversity crisis by working to complete an inventory of Earth’s plants, animals and microbes. Each year a small, dedicated community of taxonomists and curators substantively improve our understanding of the diversity of life and the wondrous ways in which species have adapted for survival.”
As of 2009, scientists have described nearly two million species (exactly 1,941,939 species), a process that began with Carolus Linnaeus in 1735. Yet despite some 275 years of discovery, scientists believe there are many more species remain undescribed on Earth than described. Estimates of Earth’s total species range from three million to 100 million, but more recent estimates have put the number in the seven to ten million bracket. Yet if microbes are added the numbers could be much, much higher, perhaps even upwards of a billion.
Yet even as we know so little about the species we share the planet with, many are likely vanishing. Scientists estimate that current extinction rates are 100 to 1,000 times the natural rate. Deforestation, habitat loss, over-consumption, climate change, and ocean acidification may mean we are entering an age of mass extinction to rival the comet that killed the dinosaurs. But still there is much left to protect and finding new species could be key as to how, according to Wheeler.
“By studying the millions of ways in which organisms have met challenges, we open a great library of possibilities for meeting our own needs more sustainably.”
Top Ten New Species of 2013

The most famous of the top ten is most definitely the olinguito (Bassaricyon neblina), which made a major media splash last year when it was announced. Living in the Andean cloud forests of Colombia and Ecuador, the olinguito is a member of the Procyonidae family, which includes raccoons, coatis, kinkajous and olingos. The olinguito, often described as a cross between a cat and a teddy bear, is the first new mammal in the carnivore family discovered from the Western Hemisphere in 35 years. Photo by: Mark Gurney.

With only an estimated 2,500 left, the dragon tree (Dracaena kaweesakii) may be the most threatened species on the list. Found in Thailand—and perhaps Myanmar—the dragon tree is distinguished by sword-shaped leaves and cream-colored flowers. It grows up to 12 meters tall and is found only in limestone hills and mountains, which are being destroyed for concrete production. Photo by: Paul Wilkin.

A new sea anemone discovered living upside down on the underside of an Antarctic glaciers has overturned the conventional wisdom on these marine creatures. Dubbed Edwardsiella andrillae, the new sea anemones were uncovered by the the Antarctic Geological Drilling Program (ANDRILL). Scientists still aren’t sure how the anemones attach themselves to the glaciers or survive in the ice, given this is a first for sea anemones. Photo by: SCINI.

This is not an alien, but a new species of skeleton shrimp, also known as ghost shrimp, only distantly related to the shrimp that shows up on our plates. This species was discovered from a cave on California’s Santa Catalina island. The new species is named Liropus minusculus, due to its extremely small size: males are only 3.3 millimeters, while females are even tinier at 2.1 millimeters. Interestingly, it is the first member of the genus Liropus discovered in the northeastern Pacific. Photo by: SINC (Servicio de Informacion y Noticias CientÌficas) and J.M. Guerra-García.

This new fungus produces a startlingly orange color when found in colonies, and, hence, has been named after Holland’s Price of Orange: Penicillium vanoranjei. Discovered from soil in Tunisia, the new fungus may prove useful in protecting against drought. Photo by: Cobus M. Visagie.

Spot the gecko? This new species was discovered during an expedition to Australia’s remote Cape Melville mountain range, along with several other species. The gecko, which blends incredibly well into its surroundings and tends to stick to the nighttime, was named the Cape Melville leaf-tailed gecko (Saltuarius eximius). Scientists believe it may be an endangered species. Photo by: Conrad Hoskin.

This is one weird new species! Although only comprised of one cell, this marine creature builds a massive shell from discarded sponge fragments, making it as long as five centimeters. From the Foraminifera phylum, this new species was discovered in underwater caves off the coast of Spain, but is only the eleventh known species in the schizaminid family. It’s also a master of mimicry: it builds its shell to look like a carnivorous sponge and even eats like one. Scientists have dubbed it: Spiculosiphon oceana. Photo by: Manuel Maldonado.
Scientists construct space craft in so-called clean rooms, in order to drastically mitigate the amount of microbes that could potentially hitch a ride to space. But no matter how clean these rooms are, life finds a way. Recently, scientists discovered a new species of microbe in two different spacecraft-building clean rooms thousands of miles apart: one in Florida and another in French Guiana. The new species, Tersicoccus phoenicis, survives on almost nothing. Scientists speculate that it inhabits extreme environments somewhere on Earth, such as deserts or caves. Photo by: Leibniz-Institute DSMZ and Jet Propulsion Laboratory, California Institute of Technology.

A new genus of fairyfly has been named after the irascible fairy in the literary classic, Peter Pan. Actually wasps, fairyflies are short-lived parasitoids in the Mymaridae family. In other words, they lay their eggs in a host’s nest. Eventually when the fairyflies hatch they eat the host’s offspring. They are also among the smallest insects in the world. This new species, Tinkerbella nana, is only 250 micrometers long. It was discovered in secondary-growth rainforest in Costa Rica. Photo by: Jennifer Read.

It’s eyeless, translucent, and moves only a few centimeters every week. Meet Zospeum tholossum, a tiny snail (2 millimeters long) discovered over 900 meters deep in the Lukina Jama-Trojama caves in Croatia. During the expedition, cavers found only one living individual of the new species, but uncovered several empty shells. Researchers hypothesize that the species may be able to move more quickly by hitching a ride on bats or cave insects or jumping into water currents. Photo by: Jana Bedek.
Related articles
Dancing frogs: scientists discover 14 new species in India (PHOTOS, VIDEO)

(05/16/2014) Scientists have discovered 14 new species of frogs in the mountainous tropical forests of India’s Western Ghats, all of which are described in a recent study published in the Ceylon Journal of Science. The new species are all from a single genus, and are collectively referred to as “dancing frogs” due to the unusual courtship behavior of the males.
Scientists uncover new marine mammal genus, represented by single endangered species
.150.jpg)
(05/14/2014) This is the story of three seals: the Caribbean, the Hawaiian, and the Mediterranean monk seals. Once numbering in the hundreds of thousands, the Caribbean monk seal was a hugely abundant marine mammal found across the Caribbean, and even recorded by Christopher Columbus during his second voyage, whose men killed several for food.
The Harry Potter wasp: public votes to name new species after soul-sucking ghouls

(05/05/2014) Whether a die-hard Harry Potter fan or not, you probably know what dementors are. They were the guards of Azkaban —dark hooded evil beings that sucked the soul out of their victims, leaving them alive but ’empty-shelled.’ These fictional creatures now share their name with a new species of cockroach wasp, insects that turn cockroaches into zombies.
Will they hold on? Three new gecko species found in threatened habitat

(05/02/2014) Malaysia is set to lose ancient limestone formations to quarrying despite the discovery of new species of geckos in the area. The species are described in three studies recently published in the journal Zootaxa. One of the discoveries, Cyrtodactylus metropolis, is the first endemic vertebrate species discovered in the Batu Caves area.
Fish-terrorizing, prehistoric-looking turtle actually three species

(04/30/2014) So, you’re a fish swimming in a river in Louisiana. Hungry, you see a little worm wiggling out from the river bed. You swoop in for the ambush only to have that little worm turn into the gaping maw of some prehistoric-looking monster out of fishy nightmares. You’ve been duped: it’s too late to escape as the beast’s jagged jaws close over you. Meet the alligator snapping turtle…or one of several species.
Loggers plan to clear 20 percent of tropical island paradise

(04/28/2014) Seven years ago, a palm oil company set its eyes on Woodlark Island—a small rainforest island nearly 200 miles off the coast of Papua New Guinea—but was rebuked by the local populace. But locals and conservationists who spoke to mongabay.com at the time felt that wouldn’t be the end of it: they were right. Recently, a company, Karridale Limited, has landed machinery on the island.
Game of thorns: colorful, spiky tree frog discovered in Vietnam

(04/25/2014) Evening fog settled quickly on Mount Ngoc Linh, as the steady drone of cicadas and crickets took up their usual nighttime chorus. The night calm was broken by sudden crashing through the thick bamboo stands and excited voices. High in this isolated cloud forest in central Vietnam, researchers had come upon the first thorny tree frog known to science.
New relative of the ‘penis snake’ discovered in Myanmar

(04/17/2014) Scientists have discovered a new species of limbless amphibians, known as caecilians, in Myanmar. Dubbing the species, the colorful ichthyophis (Ichthyophis multicolor), the researchers describe the new amphibian in a recent paper published in Zootaxa. The world’s most famous caecilian is the so-called penis snake (Atretochoana eiselti) which was rediscovered in Brazil in 2011.
Weird and mysterious: scientists find new shark species

(04/16/2014) A long snout with teeth jutting from the sides? Check. Catfish-like barbels dangling from its chin? Got them. Gills on the side of its body? It has those, too. These are characteristics of a bizarre group of sharks known as sawsharks. And until recently, only seven species were recognized. However, a new discovery raises that number by one more.
Scientist discovers a plethora of new praying mantises (pictures)

(03/19/2014) Despite their pacific name, praying mantises are ferocious top predators with powerful, grasping forelimbs; spiked legs; and mechanistic jaws. In fact, imagine a tiger that can rotate its head 180 degrees or a great white that blends into the waves and you’ll have a sense of why praying mantises have developed a reputation. Yet, many praying mantis species remain little known to scientists, according to a new paper in ZooKeys that identifies an astounding 19 new species from the tropical forests of Central and South America.
Several Amazonian tree frog species discovered, where only two existed before

(03/18/2014) We have always been intrigued by the Amazon rainforest with its abundant species richness and untraversed expanses. Despite our extended study of its wildlife, new species such as the olinguito (Bassaricyon neblina), a bear-like carnivore hiding out in the Ecuadorian rainforest, are being identified as recently as last year. In fact, the advent of efficient DNA sequencing and genomic analysis has revolutionized how we think about species diversity. Today, scientists can examine known diversity in a different way, revealing multiple ‘cryptic’ species that have evaded discovery by being mistakenly classified as a single species based on external appearance alone.
Photos: Weird aquatic lizard discovered in mountain streams of Peru
(03/13/2014) A ‘new’ species of lizard has been described from the cloud forests of Peru’s Manu National Park, reports SERNANP, the Peruvian National Park Service.







